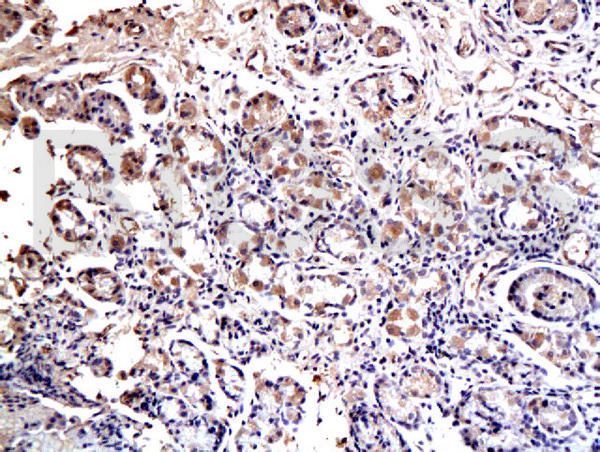

SOX2 ANTIBODY ,Each
$ 704.30
|
|
Details:
SOX2 Antibody^ SOX2 Polyclonal Antibody, Host: Rabbit, Species: Human, Mouse, Rat, Isotype: IgG, Synonymns: lcc; ysb; Sox-2; Transcription factor SOX-2; Sox2, Application: IHC-P, IF(IHC-P), 100ul
Additional Information
| SKU | 23553442 |
|---|---|
| UOM | EACH |
| UNSPSC | 12352203 |
| Manufacturer Part Number | BS-0523R |
| Product Dimensions | 10.5X7.88X7.5 Inches |
| Product Weight | 2 |

